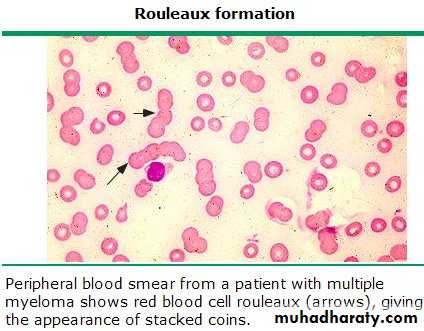

Plasma cell dyscrasia
Dr Sura Obay AldewachiAt the end of this lecture you will learn:
Multiple myeloma definition and characteristic features.Epidemiology and risk factors of multiple myeloma.
Pathogenesis and pathophysiology of multiple myeloma.
Clinical features of multiple myeloma.
Monoclonal protiens.
Major and minor criteria for multiple myeloma diagnosis.
Definition
• Multiple myeloma is a neoplastic plasma cell dyscrasia (PCD) that generally produced a monoclonal immunoglobulin protein, characterized by:• Anemia
• A monoclonal protein in the serum or urine, or both.
• Abnormal bone radiographs and bone pain
• Hypercalcemia
• Renal insufficiency or failure..
Epidemiology of Myeloma
Approximately 14,400 new cases of multiple myeloma are diagnosed each year.
The median age at diagnosis of myeloma is 71 years of age.
Men are more likely to develop the disease than woman.
Risk factors
Radiation: people who were exposed to radiation from an atomic bomb blast have increased risk of multiple myeloma.Workplace exposure: Several epidemiological studies have evaluated the risk of myeloma among agricultural workers. Workers in various metal occupations and industries have been reported to have an increased myeloma risk.
Diagnostic and Therapeutic X-rays.
Having other plasma cell diseases: many people with monoclonal gammopathy of undetermined sgnificance (MUGS) eventually develop multiple myeloma.
PATHOGENESIS AND PATHOPHYSIOLOGY
• Normally, plasma cells make up a very small portion (less than 1%) of cells in the bone marrow.• Myeloma plasma cells, however, have specific adhesion molecules on their surface allowing them to target bone marrow.
• After they enter the bone marrow, these adhesion molecules allow them to attach to structural cells called stromal cells.
• Once myeloma cells attach to bone marrow stromal cells, several interactions cause myeloma cells to grow .
• Such plasmablasts tend to increase with disease progression and may represent the dominant tumor cell population during the terminal disease phase. Tumor involvement of the marrow typically causes anemia, the degree of which appears related to tumor mass.
• Neoplastic myeloma cells may replace the normal hemopoietic tissue in the marrow.
Clinical Manifestations
The symptoms of multiple myeloma may be nonspecific and include• Fatigue.
• Bone pain.
• Easy bruising and bleeding
• Recurrent infections
• Manifestations of anemia
• Hypercalcemia
• Lytic bone lesions
• Hyperviscosity
• Infection.
• Weight loss.
• Monoclonal Proteins
• The protein (also known as M component, myeloma protein, or spike) is a hallmark of the disease; 97% of myeloma patients have an intact Ig or a free light chain that can be detected by protein electrophoresis,
Hematological abnormalities
• CBPShows normochromic normocytic morphology with marked rouleaux formation
W.B.Cs are normal
Platelets are adequate or reduced ,
Highly raised E.S.R.
Criteria For Diagnosis Of Plasma Cell Myeloma
• Major criteria• Plasmacytomas on tissue biopsy
• Marrow plasmacytosis with>30% plasma cells
• Monoclonal globulin spike on serum electrophoresis
• Minor criteria
• Marrow plasmacytosis 10-30%
• Monoclonal globulin spike present, but less than significant high level .
• Lytic bone lesions